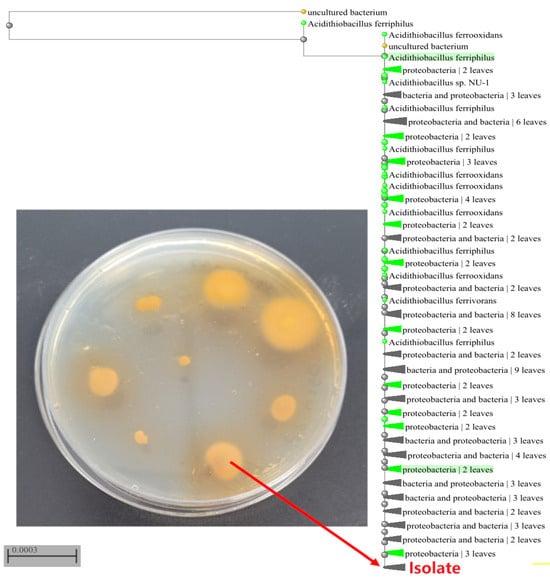

Abstract
Bioleaching, mediated by selected microflora, offers a more environmentally friendly and cost-effective alternative to traditional mining techniques by transforming metals from sulfide ores into water-soluble forms. Pyrite ores often contain valuable rare or noble metals, such as gold (Au), silver (Ag), nickel (Ni), and cobalt (Co), which can be leached through the metabolic activity of specific chemoautotrophic microorganisms. This study investigates the adaptation process of the Acidithiobacillus ferriphilus bacterial strain, originally isolated from acid mine drainage (AMD), for the bioleaching of pyrite. The progress of the bioleaching process was evidenced by the release of iron (3.6 mg/mL) and significant quantities of gold (0.21 mg/L, equivalent to 3 g/t) into the post-culture liquid. The results indicate that the most effective bioleaching was achieved during the final adaptation stage, utilizing a medium with 7% pyrite content and a 0.75% supplement of an easily accessible energy source in the form of iron sulfate. These findings confirm the potential of the A. ferriphilus strain for pyrite bioleaching.
1. Introduction
The continuous depletion of rich deposits of rare and precious metal ores has necessitated the development of new technologies to exploit deposits with lower concentrations of valuable components. Ensuring a steady supply of metals is particularly crucial for so-called Critical Raw Materials (CRMs), which the European Commission defines as “non-energy, non-agricultural raw materials that are considered to be critical due to their high economic importance and their exposure to high supply risk, often caused by a high concentration of supply from a few third countries” [1]. These valuable metals are essential for key sectors, such as the medical and electrical industries, and for the production of catalysts [2]. This global trend underscores the urgent need for new technologies that meet increasingly stringent economic and ecological standards [2,3,4]. Conventional pyrometallurgical methods for processing iron-sulfide ores release harmful sulfurous gases and toxic dust into the environment [2]. In contrast, bioleaching is a biological process that uses specific strains of bacteria to recover metals from intractable sulfide ores [5].
Furthermore, it is important to note that pyrite, when exposed to the atmosphere, can generate AMD, which is detrimental to the environment [6]. Consequently, studying the mechanisms of pyrite leaching and the role of microorganisms in this process is vital for both the mining industry and environmental protection. The microbiological processing of metal ore minerals is a central focus of modern research aimed at developing efficient metal recovery technologies deemed key, strategic, and critical for national and EU economies [7,8].
Compared to conventional pyrometallurgical methods, the bioleaching process offers numerous advantages, such as low energy and cost consumption, simple equipment, environmental friendliness, and a relatively short process duration [5]. Depending on the specific technology employed, bioleaching can achieve high recovery rates: up to 97% for Cu, 99% for Zn, 40% for Ag [9], 93% for Mo [10], and 90% for Co [11]. The most significant improvements are seen in the processing of gold ores, where the use of bacteria has increased gold recovery from a range of 30%–50% to as high as 95% [12], and, in some cases, from 5% to 91% [13]. With the gradual depletion of high-grade gold deposits, the recovery of this valuable metal from resistant ores is an inevitable direction for the future development of the gold industry [14].
Pyrite, an iron disulfide mineral (FeS2) belonging to the sulfide group, is one of the most common sulfide minerals on Earth. Its oxidation process is a key component of the global iron and sulfur cycle [15]. This mineral serves as a valuable reservoir for numerous useful metals, including copper (Cu), cobalt (Co), zinc (Zn), nickel (Ni), silver (Ag), and gold (Au) [16,17]. Pyrite is characterized by its isometric crystals, which typically form cubes, octahedrons, and pentagonal dodecahedra. Historically, the mineral was used to produce sulfuric acid; however, it is now of significant interest as a source of rare metals (nickel, cobalt, zinc, silver, gold, copper) that can be recovered through bioleaching.
The leaching of these metals from insoluble minerals is primarily driven by sulfur bacteria that are capable of oxidizing iron ions in an acidic environment. The identification of a suitable microorganism or a consortium of microorganisms is essential for developing effective biotechnological leaching processes for the recovery of rare and strategic metals [16]. The bioleaching of base metals differs from the biooxidation of gold in the method of recovery from the solution. While base metals are released into the solution through biological oxidation and can be recovered using hydrometallurgical methods (e.g., solvent extraction-electrowinning), gold bioleaching involves microorganisms liberating gold from the sulfidic mineral matrix of pyrite. This liberation step increases the accessibility of the gold to lixiviants, such as cyanide [18].
Given the significant toxicity of cyanides, alternatives such as thiourea and thiosulfate are being explored due to their high leaching rates and lower environmental impact [19]. Furthermore, current research is focused on developing methods for recovering gold from gold-bearing ores using cheap, non-toxic, and effective reagents, including biogenic lixiviants [20]. For instance, Kudpeng et al. (2020) [21] described a study on gold bioleaching from electronic waste and sulfidic gold ore concentrate, mediated by iodide-oxidizing bacteria (IOB). The results show gold leaching yields of approximately 100% and 34% for R. tolerans and R. mucosus, respectively.
Among all microorganisms involved in bioleaching, iron- and sulfur-oxidizing bacteria are the most effective [22,23,24]. A notable example is the species Acidithiobacillus ferriphilus, which are Gram-negative, iron-oxidizing chemolithoautotrophs. These organisms are highly active in bioleaching sulfide ores under extreme, acidic conditions (pH < 4). A. ferriphilus bacteria can dissolve metals either directly by secreting enzymes or indirectly through chemical processing of the sulfide ore, deriving energy from the oxidation of elemental sulfur and iron compounds [23,24,25,26]. Similarly, Thiobacillus strains produce ferric ions (Fe3+) or sulfuric acid by utilizing ferrous ions (Fe2+) or elemental sulfur (S0) as an energy source. In this process, oxygen serves as the final electron acceptor, and carbon dioxide is the sole carbon source [27].
Given the diverse microflora present in mine deposits, it is crucial to study their composition and identify bacteria with the most suitable capabilities. This knowledge is fundamental for determining the optimal bioleaching conditions and for designing the process infrastructure. The solubilization of metals from mineral ores through microorganisms represents an economically viable and ecologically sound solution, particularly for recovering metals from low-grade ore or overburden, as it requires only moderate capital investments [28].
The bioleaching of various materials, including pyrite, necessitates an adaptation procedure. This process allows microorganisms to gradually acclimate to changing environmental conditions. The iron resources within pyrite are initially difficult for the bacteria to access, making it essential to progressively replace an easily available Fe source (a divalent salt) with pyrite, which primarily contains iron(II) sulfide. Upon completion of the adaptation process, the bacteria develop the ability to decompose pyrite and release the valuable elements it contains. The bioleaching process was then carried out in the absence of easily available iron salts. The metals leached into the post-culture fluid were subsequently quantified using the phenanthroline method (for Fe) and Inductively Coupled Plasma-Optical Emission Spectrometry (ICP-OES) for other metals, including Cu, Au, Ag, Co, and Ni.
Therefore, the primary objective of this study is to investigate the microbial adaptation process for efficient pyrite bioleaching, aimed at liberating valuable metals from polymetallic deposits. To our knowledge, this is the first study in which a procedure for adapting Acidithiobacillus ferriphilus bacteria to bioleaching of raw pyrite has been developed.
2. Materials and Methods
2.1. Samples of AMD and Pyrite
The research material comprised water and sludge samples from the AMD collected at the Jerzy opencast mine. This mine exploits the Orłowice mica schist deposit, located at the northern foot of the Izera Mountains, between the health resorts of Czerniawa-Zdrój and Świeradów-Zdrój in the Western Sudetes, Lower Silesian Voivodeship, Poland. The collected AMD waters had accumulated in depressions at the bottom of the mine excavation. These solutions were formed due to the intensive weathering of sulfides from local pyritized quartz veins. This process led to the formation of hydrated sulfates (e.g., copiapite, Fe2+Fe3+4(SO4)6(OH)2·20H2O) and their subsequent migration into local surface waters, primarily as Fe3+ and SO42− ions. This phenomenon results in a gradual decrease in the pH of the solutions to values below 3, as evidenced by the presence of yellow-colored weathering products, which are characteristic of jarosite (KFe3+3(SO4)2(OH)6) formation under extremely acidic conditions [29]. The pyrite used in the study was sourced from Huanzala, Peru. Prior to experimentation, the samples were ground to a particle size of <0.065 mm. The composition of the pyrite was determined using the EDXRF X-ray fluorescence method.
2.2. Microbial Isolation and Identyfication
Bacteria were isolated from samples of AMD water and sludge. The isolation was performed using liquid 9 K medium and solidified TSM I medium, which had the following composition [g/L]: (NH4)2SO4 3.0, KCl 0.1, K2HPO4 0.5, MgSO4·7H2O 0.5, Ca(NO3)2 0.01, FeSO4·7H2O 44.3, and gellan gum 4. The pH of the medium was adjusted to 2.0 using sulfuric acid.
The culture of iron-oxidizing microorganisms was conducted in 250 mL bottles intended for adherent cultures, containing 75 mL of liquid 9 K medium. The cultures were incubated at 30 °C on a rotary shaker at 130 rpm. The resulting rust-colored precipitate was then collected, diluted, and plated onto TSM I solid medium with a selected solidifying agent. The plates were incubated for approximately one week at 30 °C. Single colonies from the solid medium were picked to obtain a pure culture and inoculated into a sterilized 9 K liquid medium. To ensure the purity of the culture, control inoculation was also performed on a solid medium. By repeating this procedure, a pure culture was successfully obtained and used for further research.
The total bacterial population was quantified using the plate count method on solidified TSM I medium. The results were expressed in colony-forming units per 1 mL of culture (CFU/mL) after a 7-day incubation period at 30 °C.
The identification of the bacterial isolate was based on the sequence analysis of the 16S rDNA. The partial gene sequence was amplified via a polymerase chain reaction (PCR) using universal primers: 27F (AGAGTTTGATCGTGGCTCAG) and 1492lR (GGTTACCTTGTTACGACT). This was performed according to a standard procedure, followed by the sequencing of the resulting product. The sequence was then compared with closely related sequences from the Ribosomal Database Project [30] and aligned using MAFT version 7. The Basic Local Alignment Search Tool (BLAST) was employed to compare the sequence of isolated strain of bacteria against the National Center for Biotechnology Information and phylogenetic tree was generated.
2.3. Strain Adaptation Procedure
The pyrite samples used for bacterial cultivation were ground and sieved to achieve a particle size of less than 0.065 mm. These prepared samples were then used to optimize the cultivation of the isolated strain and for subsequent bioleaching experiments. The medium used was a 9 K mineral salt solution with the following composition [g/L]: (NH4)2SO4 3.0, KCl 0.1, K2HPO4 0.5, MgSO4·7H2O 0.5, Ca(NO3)2 0.01, and FeSO4·7H2O 44.3 (pH = 2).
To adapt the microorganisms to the culture conditions and to achieve maximum metal bioleaching, the experiments were performed following a 4-step adaptation protocol, with each stage lasting two weeks. The concentration of FeSO4·7H2O was gradually reduced from 2.5% to 0.75%, while the pyrite concentration was increased from 1% to 7% to serve as the primary energy source. This corresponds to a solid-to-liquid ratio ranging from 1:100 to 1:14. The pH of the medium was adjusted to 2.0 with sulfuric acid.
2.4. Bioleaching of Pyrite
The final bioleaching step was conducted over a period of three weeks using 90 g/L of pyrite, which corresponded to a solid-to-liquid ratio of 1:11. This experiment was performed without the addition of ferric (Fe3+) sulfate. The experiments were carried out in 250 mL Erlenmeyer flasks.
Each flask was prepared with 90 mL of 9 K medium containing 90 g/L of pyrite, which had been dried to a constant weight at 105 °C. This pyrite served as the sole source of iron. The initial pH of the medium was adjusted to 2.0 with sulfuric acid (H2SO4). The flasks were then inoculated with 10 mL of a bacterial inoculum in the logarithmic growth phase, with a cell density of 1.7 × 107 CFU/mL. A parallel uninoculated sample was used as an acid leaching control. All flasks were incubated in the same incubator at 30 °C on a rotary shaker at 130 rpm. Each set of experiments was performed in triplicate.
2.5. EDX
The preliminary determination of the chemical composition of the mineral material was performed using semi-quantitative analysis with a Shimadzu EDX-7000 energy-dispersive X-ray fluorescence (EDXRF) spectrometer (Kyoto, Japan). Before measurement, the rock samples underwent initial preparation, which included air-drying at ambient temperature, impact crushing, and powdering with an IKA M 20 universal mill (Kobayashi, Japan). The samples were then manually sieved using a standard laboratory sieve with a nominal mesh size of 0.1 mm to obtain the desired particle size fraction (<100 µm).
To ensure sample homogeneity, weighed quantities of the components—specifically, 2.25 g ± 0.1 g of the powdered rock material and 0.75 g ± 0.1 g of a boric acid binding agent—were pressed into disks. The components were mechanically mixed and homogenized for approximately one minute in a porcelain mortar to achieve a uniform distribution of the binder throughout the sample volume. The resulting mixture was then placed in the manual die of a Specac Atlas™ (Orpington, UK). Manual hydraulic press. The pressing process was conducted under a pressure of 15 tons for 3 min, yielding disks with sufficient mechanical strength and structural uniformity, both of which are essential for precise EDXRF analysis. The prepared pellets were subsequently analyzed using a EDXRF spectrometer.
2.6. XRD
The XRD (X-Ray Diffraction) analysis of three pyrite samples—an unprocessed sample, a control sample, and a sample subjected to microbiological solubilization—was performed as part of an external order at Wrocławski Park Technologiczny S.A., Wrocław, Poland.
The XRD patterns were collected using a Rigaku MiniFlex600 diffractometer (Neu-Isenburg, Germany) with Cu Kα radiation (λ = 1.5406 Å). The samples were measured using θ–2θ scans. The instrument was equipped with a copper anode and a graphite monochromator to select the Cu Kα radiation (2θ 5–50 deg). The diffractograms were scanned using 0.1 deg steps with a counting time of 1 s per step.
2.7. ICP-OES
The concentrations of copper (Cu), nickel (Ni), and gold (Au) in the post-culture fluids from both the strain adaptation and final bioleaching processes were determined at the NU-2 Water Chemical Research Laboratory. The analysis was performed using an ICP-OES OPTIMA 2000DV Perkin Elmer spectrometer (Shelton, WA, USA).
The specific instrument settings were as follows: RF power at 1200 W; argon (Ar) flow rates of 15.0 dm3/min for plasma, 1.5 dm3/min for the auxiliary gas, and 0.75 dm3/min for the nebulizer. The sample collection delay was 30 s, the rinsing time was 15 s, and the reading was repeated three times with a 1 s interval between repetitions. Standard solutions used for the analysis included Merck Certipur (1000 mg/L) for Cu, Ni, Ag, and Co, and Supelco Certipur (1000 mg/L) for Au.
2.8. SEM
The SEM (Scanning Electron Microscopy) images of three pyrite samples—an unprocessed sample, a control sample, and a sample subjected to microbiological solubilization—were acquired through an external order carried out at the University of Wrocław, Institute of Geological Sciences, Department of Mineralogy and Petrology.
Imaging was performed in Secondary Electrons (SE) mode using a Jeol JSM-IT500LA scanning electron microscope (Tokyo, Japan). This method enables the observation of the sample’s surface morphology under high-vacuum conditions.
2.9. Analytical and Physicochemical Methods
The total concentration of iron ions (Fe2+, Fe3+) was measured using the o-phenanthroline method at an absorption wavelength of 510 nm [31]. The oxidation-reduction potential (ORP) was determined using a platinum (Pt) electrode relative to an Ag/AgCl reference electrode, and the solution’s acidity (pH) was measured with a combined pH electrode once the suspension reached room temperature. The dry weight of pyrite was ascertained using the gravimetric method at 105 °C. All analyses were conducted in triplicate.
3. Results and Discussion
3.1. Isolation and Identification of Bacterial Strain
Samples of AMD water were collected from weathered sulfide mineralized zones. The average pH of these samples was measured at 2.90. To isolate the AMD bacteria, a 9 K medium supplemented with ferrous sulfate was used. Following a two-week agitated culture (130 rpm) at 30 °C, the formation of a rusty precipitate was observed. This precipitate confirmed the presence of chemoautotrophic microorganisms capable of oxidizing the ferrous iron (Fe2+) in the medium, utilizing this process as their source of metabolic energy. The resulting culture fluid was then inoculated onto a solidified TSM I medium (Figure 1).
Figure 1.
A 14-day plate culture of the bacterial isolate on solidified 9 K medium, which was supplemented with iron sulfate and gellan gum and phylogenetic tree, comparing similarities in the 16S rRNA gene sequence of bacteria, showing the relationship of the isolated strain (isolate) and other strains of the Acidithiobacillus ferriphilus species.
The sequenced sample exhibited 100% similarity to the sequence KY002491.1 of Acidithiobacillus ferriphilus, a species closely related to Acidithiobacillus ferrooxidans. Bacteria of the species A. ferriphilus are classified as mesophilic microorganisms. According to a study by Falagán and Johnson (2016) [32], 11 strains of A. ferriphilus were investigated. These strains were found to catalyze the dissimilatory oxidation of iron, elemental sulfur, and tetrathionate, as well as the oxidative dissolution of pyrite under aerobic conditions. Furthermore, all strains also catalyzed the dissimilatory reduction in ferric iron under anaerobic conditions, using reduced sulfur as an electron donor.
3.2. Acidithiobacillus Ferriphilus Adaptation Procedure
The bioleaching process requires the microorganism to be pre-adapted to the specific process conditions. This is achieved by gradually reducing the nutrient concentration in the substrate, which also contains the material to be leached. This procedure facilitates the microorganism’s adaptation to obtain energy through ore decomposition and the simultaneous release of valuable trace elements. For instance, Noruzi et al. (2022) [33] described a bioleaching process for used batteries, which was preceded by an adaptation procedure for the strains Acidithiobacillus ferriphilus and Acidithiobacillus thiooxidans. In their study, adaptation to silver ions enhanced the strains’ capability for cobalt (Co) and nickel (Ni) extraction, achieving a remarkable 99.95% recovery rate in a two-step bioleaching process.
The efficiency of the bioleaching process is influenced by various factors, including the oxidation-reduction potential (ORP), which can significantly impact the leaching of specific metals. The ORP recorded in the inoculated culture was, on average, 10 mV higher than that of the uninoculated control (Figure 2). Furthermore, a gradual increase in this parameter was observed as the adaptation process progressed, reaching a value of 314 mV at stage 4. These values are lower than those reported by other researchers; for example, Zhang et al. (2008) [34] achieved a redox potential of 500 mV for an A. ferriphilus strain. While a high redox potential is generally considered beneficial for pyrite bioleaching, other studies present a more nuanced view. Third et al. (2002) [35] controlled the solution potential by limiting oxygen during chalcopyrite bioleaching and concluded that a constant ORP of 380 mV was responsible for high copper extraction. Similarly, Zhao et al. (2015) [36,37] found that chalcopyrite dissolution was accelerated within a redox potential range of 390–480 mV, with copper extraction being relatively low outside this range. Low redox potential values (around 300 mV) were also described by Kudpeng et al. (2020) [21] during the bioleaching of gold from sulfidic ore concentrate using R. tolerans and R. mucosus.

Figure 2.
pH (a) and oxidation-reduction potential (b) of the culture medium during the adaptation of the A. ferriphilus strain. Each adaptation stage lasted two weeks (for a total of eight weeks).
During the adaptation of the A. ferriphilus strain, a gradual acidification of the culture medium was observed (Figure 2). This acidification, which was more intense than in the uninoculated control, was related to microbial activity. This parameter changed spontaneously and was not corrected. Although the bioleaching process lowers the pH, which is favorable for its efficiency, it can have an adverse effect on the bacteria themselves [35].
The concentration of ferrous (Fe2+) iron ions in the inoculated adaptive culture increased over time, though a similar trend was also observed in the non-inoculated control (Figure 3). Despite the decreasing dose of soluble ferrous salt in subsequent stages, the concentration of iron ions continued to rise, which may indicate that the pyrite bioleaching process was taking place. A slight increase in iron ion concentration in the control samples suggests the influence of abiotic factors on the leaching process, possibly related to the oxygenation of the medium during flask agitation.

Figure 3.
Iron concentration in the medium of adaptive cultures of the A. ferriphilus strain. Each adaptation stage lasted two weeks (for a total of eight weeks).
3.3. Pyrite Bioleaching
In the subsequent stage of the research, pyrite bioleaching was conducted without the addition of iron salts as a source of ferrous (Fe2+) ions. The control experiment consisted of flasks containing 9 K medium and pyrite (9 g/100 mL). The changes in the redox potential during pyrite bioleaching were insignificant, maintaining a low value of 306 mV. This was notably lower than the results obtained during the strain’s adaptation process (Figure 2 and Figure 4). The solution’s redox potential is a critical indicator of the pyrite bioleaching process and correlates with its dissolution rate. It is primarily dependent on the activity of ferrous (Fe2+) and ferric (Fe3+) ions, and it tends to increase when ferric ions predominate. However, pyrite oxidation is only detectable at a redox potential above 660 mV, as the mineral remains inert at low redox potential values [38,39,40]. Furthermore, the pH of the medium, in both the inoculated culture and the control, did not show any decreasing trend (Figure 4). This is a condition that is not conducive to the bioleaching process.

Figure 4.
pH (a) and oxidation-reduction potential (b) of the culture medium during the pyrite bioleaching with the use of the A. ferriphilus strain.
Despite these unfavorable physicochemical parameters, a significant increase in the concentration of iron ions (3.56 mg/mL) was observed in the culture of the A. ferriphilus strain on pyrite after 20 days (Figure 5), which indicates the progression of the bioleaching process. Similar trends in pH and ORP changes were described by Min et al. (2015) [41], who studied the bioleaching of multiple heavy metals from contaminated sediment. Their research used a mesophilic consortium of three bacterial strains: Acidithiobacillus ferrooxidans, Acidithiobacillus thiooxidans, and Leptospirillum ferriphilum. In that study, flask experiments investigated the influence of the sulfur-to-pyrite ratio on the bioleaching process. A similar ORP range (300–370 mV) was observed from day 2 to day 14 across different sulfur-to-pyrite ratios, except for the test without pyrite (a sulfur-to-pyrite ratio of 2:0, where ORP was approximately 531 mV). The authors concluded that the concentration of pyrite led to a greater acidification potential in the later stages of the process. Observations from this research confirmed that bioleaching occurred despite the relatively low ORP during the process, as evidenced by the increasing iron concentration in the samples (200–650 mg Fe/L). This phenomenon can be explained by the incomplete oxidation of iron(II), which results in a high Fe2+/Fe3+ ion ratio and a correspondingly low redox potential. It is likely that the percentage of ferrous-oxidizing bacteria was either insufficient, or their oxidation ability was inhibited during this period.

Figure 5.
Iron concentration in the substrate during pyrite bioleaching with the participation of the A. ferriphilus strain.
The relatively high iron content in the post-culture fluid demonstrates the effectiveness of the bioleaching process. Given the absence of a source of ferrous or ferric ions in the culture medium, the total iron concentration after leaching originated exclusively from the pyrite, providing a direct measure of its leaching rate. A similar iron bioleaching efficiency from chalcopyrite was reported by Vardanyan and Vardanyan (2016) [42], who achieved 3.1 g/L of Fe leaching over 16 days during mixotrophic cultivation (with 0.05% yeast extract) of the S. thermosulfidoxidans strain.
3.4. Chemical and XRD Analysis of the Pyrite Sample
A thorough understanding of the mineralogical composition of an ore is crucial for comprehending and optimizing the processes of microbiological dissolution, such as pyrite bioleaching [43]. Table 1 presents the chemical composition of the tested pyrite sample, which primarily consists of 30% iron, 61% sulfur, and 6% silica. The remaining components, constituting less than 3%, are minor admixtures of other elements. Among these, the largest shares are aluminum (0.93%), calcium (0.48%), and copper (0.38%). Nickel (Ni), cobalt (Co), and gold (Au) were not detected in the sample, likely because their concentrations were below the lower detection limit of the method used.

Table 1.
EDX compositional analysis of pyrite [wt.%].
The XRD result (Figure 6) of the crushed sample was typical of what was expected for pyrite, it contained trace amounts of quartz. The XRD patterns of the pyrite attributed, respectively, to 111, 200, 210, 211, 220, 311, 222, 230, and 321 (JCPDS card n°028-0076; space group Pa3) [44]. A sample of pyrite was compared to a sample of marcasite. Both minerals are dimorphs, which means they have the same chemical formula (FeS2) but different crystal structures. X-ray diffractograms of A. ferriphilus residues after contact with a pyrite sample show that its peaks weaken (Figure 6), which, however, is not convincing evidence of biological activity. During bioleaching, iron precipitates and the ongoing process reduces the leaching rate of this element.

Figure 6.
XRD result of pyrite bioleaching after the process; untreated pyrite; pyrite from uninoculated control (abiotic control); pyrite bioleached with A. ferriphilus strain; reference (marcasite).
Additionally, changes in bioleached pyrite were visualized using a SEM image (Figure 7). Control sample has smooth surface and irregular objects on the surface (Figure 7a). In the inoculated pyrite sample, small holes were visible, which may indicate the activity of microorganisms (Figure 7b).

Figure 7.
SEM pictures with magnification 2000× for the raw pyrite (a) and bioleached pyrite sample (b).
3.5. Bioleached Metals Content
During both the adaptation phase and the pyrite bioleaching process with the A. ferriphilus strain, the elements nickel (Ni), cobalt (Co), and silver (Ag) were either not recovered or were obtained in very small quantities (Table 2). These elements were also not detected in the EDX compositional analysis of the pyrite, likely because their concentrations were below the detection limit of this method. While a small amount of Ni (0.36 mg/L) was detected in the post-culture fluid after the adaptation stage, its presence in the control sample indicates that this was an abiotic leaching process.

Table 2.
Metal content in pyrite samples.
Bioleaching of copper from pyrite was also inefficient, with relatively low amounts of this metal being recovered (13–25 mg/L), corresponding to 5%–7% of the pyrite’s dry mass. However, significant amounts of gold (Au) were detected in both the strain adaptation phase (0.21 mg/L) and the raw pyrite bioleaching stage (0.19 mg/L). Daibova et al. (2019) [2] reported a gold bioleaching efficiency of 87.83% from pyrite wastes, based on a total content of 1.15 g/t in the leached material. As a result, the authors recovered approximately 1 g/t Au. In our study, a significantly higher recovery of this valuable element was achieved, at a level of 3 g/t (0.21 mg/L).
4. Conclusions
A bacterial strain identified as A. ferriphilus was isolated from water and sludge originating from the weathering of iron sulfides at the excavation site of the Jerzy mica schist mine in Orłowice. This study determines its morphological and physiological characteristics and confirms its ability to bioleach pyrite. Through an adaptation procedure, the tested A. ferriphilus strain was successfully adapted for pyrite bioleaching. The high concentrations of gold and iron in the post-culture fluid serve as an indicator of the bacteria’s high activity and their capacity to dissolve pyrite. The adapted strain could potentially be used for bioleaching pyrites from other sources; however, the process itself requires further optimization to increase its overall efficiency.
Author Contributions
Conceptualization, J.S.-B., A.C.-P. and M.K.; methodology, A.C.-P. and M.K.; software, A.C.-P.; validation, A.C.-P., J.S.-B. and M.K.; formal analysis, A.C.-P.; investigation, J.S.-B.; resources, M.K.; data curation, J.S.-B.; writing—original draft preparation, A.C.-P. and J.S.-B.; writing—review and editing, A.C.-P. and J.S.-B.; visualization, A.C.-P.; supervision, J.S.-B.; project administration, M.K.; funding acquisition, A.C.-P. All authors have read and agreed to the published version of the manuscript.
Funding
The formal basis of the study is the order No. 33/19/16-7-013/N, implemented within the statutory activities of the “Poltegor-Institute”, Wrocław, Poland.
Data Availability Statement
Data are contained within the article.
Acknowledgments
The authors thank the Jerzy opencast mine, which exploited the Orłowice mica schist deposit, located on the north foot of the Izera Mts., between health resorts of Czerniawa-Zdrój and Świeradów-Zdrój (Western Sudetes, Lower Silesian Voivodeship, Poland) for enabling AMD samples to be collected for testing.
Conflicts of Interest
The authors declare no conflicts of interest.
Abbreviations
The following abbreviations are used in this manuscript:
| ADM | Acid mine drainage |
References
- Establishing a framework for ensuring a secure and sustainable supply of critical raw materials and amending Regulations (EU) 168/2013, (EU) 2018/858, 2018/1724 and (EU) 2019/1020. In Regulation of the European Parliament and of the Council; European Union: Brussels, Belgium, 2023.
- Daibova, E.B.; Lushchaeva, I.V.; Sachkov, V.I.; Karakchieva, N.I.; Orlov, V.V.; Medvedev, R.O.; Nefedov, R.A.; Shplis, O.N.; Sodnam, N.I. Bioleaching of Au-Containing Ore Slates and Pyrite Wastes. Minerals 2019, 9, 643. [Google Scholar] [CrossRef]
- Jarosiński, A.; Kulczycka, J. Possibilities of Obtaining Certain Critical Raw Materials in Poland in the Contex of Circular Economy Implementation. J. Pol. Miner. Eng. Soc. 2018, I–VI, 315–324. [Google Scholar] [CrossRef]
- Smakowski, T.J. Critical or deficit mineral commodities for EU and Poland economy. Zesz. Nauk. Inst. Gospod. Surowcami Miner. I Energetycznymi PAN 2011, 81, 59–68. [Google Scholar]
- Shen, L.; Cheng, J.; Wang, J.; Zhang, Y.; Zhou, H.; Wu, X.; Li, J.; Zeng, W. Biofilm formation and development during the pyrite bioleaching of moderately thermophilic microorganisms. Hydrometallurgy 2023, 222, 106183. [Google Scholar] [CrossRef]
- Dong, B.; Jia, Y.; Tan, Q.; Sun, H.; Ruan, R. Contributions of Microbial “Contact Leaching” to Pyrite Oxidation under Different Controlled Redox Potentials. Minerals 2020, 10, 856. [Google Scholar] [CrossRef]
- Mikulski, S.Z.; Oszczepalski, S.; Sadłowska, K.; Chmielewski, A.; Małek, R. The occurrence of associated and critical elements in the selected documented Zn-Pb, Cu-Ag, Fe-Ti-V, Mo-Cu-W, Sn, Au-As and Ni deposits in Poland. Biul. Państwowego Inst. Geol. 2018, 472, 21–52. [Google Scholar] [CrossRef]
- Radwanek-Bąk, B.; Galos, K.; Nieć, M. Pivotal, strategic and critical mineral raw materials for the Polish economy. Przegląd Geol. 2018, 66, 153–159. [Google Scholar]
- Olson, G.J.; Brierley, J.A.; Brierley, C.L. Bioleaching review part B: Progress in bioleaching: Application of microbial processes by the mineral industries. Appl. Microbiol. Biotechnol. 2003, 63, 249–257. [Google Scholar] [CrossRef] [PubMed]
- Nasernejad, B.; Kaghazchi, T.; Edrisi, M.; Sohrabi, M. Bioleaching of molybdenum from low-grade copper ores. Process Biochem. 1999, 35, 437–440. [Google Scholar] [CrossRef]
- Brierley, J.A.; Brierley, C.L. Present and future commercial applications of biohydrometallurgy. Hydrometallurgy 2001, 59, 233–239. [Google Scholar] [CrossRef]
- Rawlings, D.E. Industrial practise and the biology of leaching of metals from ores the 1997 Pan Labs Lecture. J. Ind. Microbiol. Biotechnol. 1998, 20, 268–274. [Google Scholar] [CrossRef]
- Hutchins, S.R.; Brierley, J.A.; Brierley, C.L. Microbial pretreatment of refractory sulfide and carbonaceous ores improves the economics of gold recovery. Min. Eng. 1988, 40, 249–254. [Google Scholar]
- Wang, S.; Wu, J.; Jiao, F. Pretreatment and Extraction of Gold from Refractory Gold Ore in Acidic Conditions. Minerals 2025, 15, 340. [Google Scholar] [CrossRef]
- Lundgren, D.; Silver, M. Ore Leaching by Bacteria. Annu. Rev. Microbiol. 1980, 34, 263–283. [Google Scholar] [CrossRef] [PubMed]
- Suzuki, I. Microbial leaching of metals from sulfide minerals. Biotechnol. Adv. 2001, 19, 119–132. [Google Scholar] [CrossRef] [PubMed]
- Yan, L.; Guo, X.; Fan, Y.; Huang, J.; Zuo, T.; Zhou, T. The occurrence of cobaltite nanoparticles in pyrite from the De’erni deposit, NW China. Ore Geol. Rev. 2024, 173, 106268. [Google Scholar] [CrossRef]
- Roberto, F.F.; Schippers, A. Progress in bioleaching: Part B, applications of microbial processes by the minerals industries. Appl. Microbiol. Biotechnol. 2022, 106, 5913–5928. [Google Scholar] [CrossRef]
- Li, Q.; Shen, H.; Xu, R.; Yan Zhang, Y.; Yang, Y.; Xu, B.; Jiang, T.; Yin, H. Effect of Acidithiobacillus ferrooxidans and Leptospirillum ferrooxidans on preg-robbing of gold by graphite from thiourea leaching solution. J. Clean. Prod. 2020, 261, 121122. [Google Scholar] [CrossRef]
- Jorjani, E.; Sabzkoohi, H.A. Gold leaching from ores using biogenic lixiviants—A review. Curr. Res. Biotechnol. 2022, 4, 10–20. [Google Scholar] [CrossRef]
- Kudpeng, K.; Bohu, T.; Morris, C.; Thiravetyan, P.; Kaksonen, A.H. Bioleaching of Gold from Sulfidic Gold Ore Concentrate and Electronic Waste by Roseovarius tolerans and Roseovarius mucosus. Microorganisms 2020, 8, 1783. [Google Scholar] [CrossRef]
- Liu, H.; Gu, G.; Xu, Y. Surface properties of pyrite in the course of bioleaching by pure culture of Acidithiobacillus ferriphilus and a mixed culture of Acidithiobacillus ferriphilus and Acidithiobacillus thiooxidans. Hydrometallurgy 2011, 108, 143–148. [Google Scholar] [CrossRef]
- Singh, S.; Sukla, L.B.; Mishra, B.K. Extraction of copper from Malanjkhand low-grade ore by Bacillus stearothermophilus. Indian. J. Microbiol. 2011, 51, 477–481. [Google Scholar] [CrossRef] [PubMed][Green Version]
- Kamizela, T.; Grobelak, A.; Worwag, M. Use of Acidithiobacillus thiooxidans and Acidithiobacillus ferriphilus in the Recovery of Heavy Metals from Landfill Leachates. Energies 2021, 14, 33–36. [Google Scholar] [CrossRef]
- Yévenes, L.V.; Malverde, S.; Quezad, V. A Sustainable Bioleaching of a Low-Grade Chalcopyrite Ore. Minerals 2022, 12, 487. [Google Scholar] [CrossRef]
- Quatrini, R.; Appia-Ayme, C.; Denis, Y.; Jedlicki, E.; Holmes, D.S.; Bonnefoy, V. Extending the models for iron and sulfur oxidation in the extreme acidophile Acidithiobacillus ferriphilus. BMC Genom. 2009, 10, 394. [Google Scholar] [CrossRef]
- Chan, L.C.; Gu, X.Y.; Wong, J.W.C. Comparison of bioleaching of heavy metals from sewage sludge using iron- and sulfur-oxidizing bacteria. Adv. Environ. Res. 2003, 7, 603–607. [Google Scholar] [CrossRef]
- Fu, B.; Zhou, H.; Zhang, R.; Qiu, G. Bioleaching of chalcopyrite by pure and mixed cultures of Acidithiobacillus spp. and Leptospirillum ferriphilum. Int. Biodeterior. Biodegrad. 2008, 62, 109–115. [Google Scholar] [CrossRef]
- Migaszewski, Z.M.; Gałuszka, A. Pierwiastki ziem rzadkich w kwaśnych wodach kopalnianych—Zarys problematyki. Przegląd Geol. 2019, 67, 105–114. [Google Scholar] [CrossRef]
- Cole, J.R.; Wang, Q.; Fish, J.A.; Chai, B.; McGarrell, D.M.; Sun, Y.; Brown, C.T.; Porras-Alfaro, A.; Kuske, C.R.; Tiedje, J.M. Ribosomal Database Project: Data and tools for high throughput rRNA analysis. Nucleic Acids Res. 2014, 42, D633–D642. [Google Scholar] [CrossRef]
- Caldwell, D.H.; Adams, R.B. Colorimetric Determination of Iron in Water with o-Phenanthroline. J. Am. Water Work. Assoc. 1946, 38, 727–730. Available online: https://www.jstor.org/stable/23349093 (accessed on 13 January 2025). [CrossRef]
- Falagán, C.; Johnson, D.B. Acidithiobacillus ferriphilus sp. nov., a facultatively anaerobic iron- and sulfur-metabolizing extreme acidophile. Int. J. Syst. Evol. Microbiol. 2016, 66, 206–211. [Google Scholar] [CrossRef]
- Noruzi, F.; Nasirpour, N.; Vakilchap, F.; Mousavi, S.M. Complete bioleaching of Co and Ni from spent batteries by a novel silver ion catalyzed process. Appl. Microbiol. Biotechnol. 2022, 106, 5301–5316. [Google Scholar] [CrossRef] [PubMed]
- Zhang, L.; Qiu, G.; Hu, Y.; Sun, X.; Li, J.; Gu, G. Bioleaching of pyrite by A. ferriphilus and L. ferriphilum. Trans. Nonferrous Met. Soc. China 2008, 18, 1415–1420. [Google Scholar] [CrossRef]
- Third, K.A.; Cord-Ruwisch, R.; Watling, H.R. Control of the redox potential by oxygen limitation improves bacterial leaching of chalcopyrite. Biotechnol. Bioeng. 2002, 78, 433–441. [Google Scholar] [CrossRef] [PubMed]
- Zhao, H.; Wang, J.; Gan, X.; Zheng, X.; Tao, L.; Hu, M.; Li, Y.; Qin, W.; Qiu, G. Effects of pyrite and bornite on bioleaching of two different types of chalcopyrite in the presence of Leptospirillum ferriphilum. Bioresour. Technol. 2015, 194, 28–35. [Google Scholar] [CrossRef]
- Zhao, H.; Wang, J.; Qin, W.; Hu, M.; Qiu, G. Electrochemical dissolution of chalcopyrite concentrates in stirred reactor in the presence of Acidithiobacillus ferriphilus. Int. J. Electrochem. Sci. 2015, 10, 848–858. [Google Scholar] [CrossRef]
- Bouffard, S.; Riveravasquez, B.; Dixon, D. Leaching kinetics and stoichiometry of pyrite oxidation from a pyrite–marcasite concentrate in acid ferric sulfate media. Hydrometallurgy 2006, 84, 225–238. [Google Scholar] [CrossRef]
- Qian, G.; Fan, R.; Short, M.; Schumann, R.; Li, J.; Smart, R.; Gerson, A. The Effects of Galvanic Interactions with Pyrite on the Generation of Acid and Metalliferous Drainage. Environ. Sci. Technol. 2018, 52, 5349–5357. [Google Scholar] [CrossRef]
- Liu, C.; Jia, Y.; Sun, H.; Tan, Q.; Niu, X.; Leng, X.; Ruan, R. Limited role of sessile acidophiles in pyrite oxidation below redox potential of 650 mV. Sci. Rep. 2017, 7, 5032–5040. [Google Scholar] [CrossRef]
- Min, G.; Zhou, S.; Li, M.; Zhu, J.; Liu, X.; Chai, L. Bioleaching of multiple heavy metals from contaminated sediment by mesophile consortium. Environ. Sci. Pollut. Res. Int. 2014, 22, 5807–5816. [Google Scholar] [CrossRef]
- Vardanyan, A.S.; Vardanyan, S.; Markosyan, N.; Sand, L.; Vera, W.; Ruiyong, M.Z. Study and assessment of microbial communities in natural and commercial bioleaching systems. Miner. Eng. 2015, 81, 167–172. [Google Scholar] [CrossRef]
- Conic, V.; Rajčić-Vujasinović, M.; Trujić, V.; Cvetkovski, V. Copper, zinc, and iron bioleaching from polymetallic sulphide concentrate. Trans. Nonferrous Met. Soc. China 2014, 24, 3688–3695. [Google Scholar] [CrossRef]
- Sai, R.; Abumousa, R.A. Impact of Iron Pyrite Nanoparticles Sizes in Photovoltaic Performance. Coatings 2023, 13, 167. [Google Scholar] [CrossRef]
Disclaimer/Publisher’s Note: The statements, opinions and data contained in all publications are solely those of the individual author(s) and contributor(s) and not of MDPI and/or the editor(s). MDPI and/or the editor(s) disclaim responsibility for any injury to people or property resulting from any ideas, methods, instructions or products referred to in the content. |
© 2025 by the authors. Licensee MDPI, Basel, Switzerland. This article is an open access article distributed under the terms and conditions of the Creative Commons Attribution (CC BY) license (https://creativecommons.org/licenses/by/4.0/).